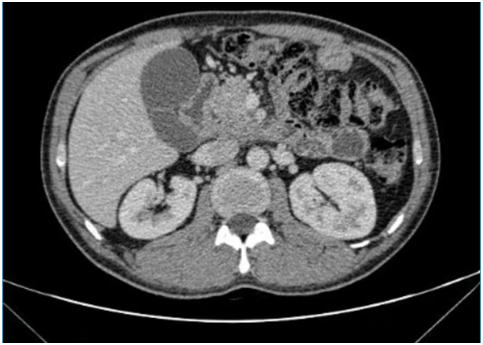

胰腺癌,素有“癌王”之称。它起病隐匿,早期症状不典型,可能仅是上腹隐痛,极易被误认为胃病。许多患者确诊时已属晚期,失去手术切除机会。
然而,对于部分局部晚期胰腺癌患者,可采用纳米刀消融(不可逆电穿孔技术) 的治疗方式,为治疗带来新的曙光。
什么是纳米刀?
纳米刀消融,又名不可逆电穿孔(IRE),是一种用于治疗实体肿瘤的新型治疗方法。
1.非热消融疗法:相比于微波消融或射频消融,纳米刀并不产生热量,也就不会对组织产生热损伤;
2.选择性消融:此外纳米刀还具有对组织“选择性消融”的特点,在破坏肿瘤细胞的同时不会破坏大血管、神经、胆道、肠道等其他重要结构;
3.诱导细胞凋亡而非“坏死”。纳米刀术后可以激发体内抗肿瘤免疫反应,可与其他辅助治疗(化疗等)起协同作用。
绝境中的寻找:一位37岁青年的求生之路
37岁的小陈,因恶心呕吐、腹胀查出胰腺中分化腺癌。肿瘤位置凶险,周围组织侵犯严重,已经引起十二指肠梗阻,无法进食。外院专家判断已无法手术,生存期可能仅剩三个月。
希望渺茫,但小陈和家人没有放弃。多方查询后,他们慕名来到郑州大学第五附属医院肝胆胰腺外科,找到了陈艳军主任团队。
初到医院时,小陈的病情确实棘手。入院CT、MRI提示:胰头颈部胰腺癌并周围侵犯;肿瘤已经包绕侵犯了几支重要血管:门静脉主干、脾静脉、胃左动脉、肠系膜上动静脉、下腔静脉,并且可见病灶周围及肠系膜根部多发淋巴结。陈艳军主任仔细评估后,制定了“先调整,后消融”的策略:先行全身化疗联合免疫治疗,争取控制肿瘤发展,为后续治疗创造可能。

在团队的精心治疗与呵护下,奇迹出现了。多次行化疗和免疫治疗后,复查CT显示肿瘤明显缩小!时机成熟,陈主任当机立断:可以行纳米刀消融术!
精准“围剿”,成功消融
经过肿瘤科、营养科、病理科等多学科团队(MDT)周密讨论与术前准备,手术如期进行。
术中,在超声的精确引导下,陈艳军主任团队巧妙避开重要血管与胆管,将纳米刀探针精准布控于肿瘤区域。通过多次调整角度、实施多点消融,实现了对肿瘤及其浸润区域的充分毁损。手术过程顺利,患者生命体征平稳。


术后,小陈恢复良好,未出现胰瘘、出血、感染等严重并发症。影像复查确认肿瘤已完全消融。在陈艳军主任团队及林磊护士长护理团队的精心照护下,他精神状态焕然一新,重拾了生活的信心。陈艳军主任诊疗团队将对其进行长期随访,持续关注后续情况。
科室介绍:肝胆胰腺外科
郑州大学第五附属医院肝胆胰腺外科技术力量雄厚,人才结构合理,拥有外科手术、射频消融、腹腔镜微创和肿瘤综合介入治疗为一体的多学科专家团队,设有肿瘤射频治疗中心,纳米刀国际培训中心河南分中心,微创治疗中心,分子诊断及靶向治疗研究基地。其中教授、主任医师1人,副教授、副主任医师2名,硕士研究生导师3名,主治医师及主管护师12名,中高级职称人员占80%以上,已培养硕士研究生10余名,长期承担郑州大学研究生、本科生的理论课程及临床实践教学任务。科室成熟开展肝胆胰腺肿瘤多学科协作综合治疗(MDT),成熟开展高难度复杂肝脏肿瘤切除手术(包括中央型肝癌切除、肝右三叶切除、扩大左半肝切除);肝门部胆管癌根治及扩大根治手术;肝内外胆管结石及胆道狭窄的手术治疗;高位胆道损伤一期整形修复重建;胰十二指肠切除术、中段胰腺肿瘤切除术、胰体尾肿瘤切除术、胰管切开取石并胰管-空肠吻合术;门脉高压症断流与分流术;布加综合征下腔静脉球囊扩张术、人工血管搭桥术、转流及根治性隔膜切除手术;腹腔镜胆囊切除术、腹腔镜下腹股沟疝修补术(TAPP、TEP)、经腹腔镜结直肠癌根治术;原发性、转移性肝癌及不可切除胰腺癌的纳米刀消融及射频消融手术;肝动脉介入栓塞治疗中晚期肝癌等手术。科室设有床位60张,拥有美国纳米刀肿瘤治疗系统(Nanoknife System)、美国强生公司超声切割止血刀、美国泰科公司及RITA公司射频消融治疗系统、北京Welfare电脑控制多极肿瘤射频消融系统、德国进口腹腔镜系统、日本PENTAX纤维胆道镜、SW—智能化心电监护仪、术中B超等先进设备。我科室在肝胆胰腺外科疾病的科研、教学、临床多个方面,达到国内先进水平。科室汇集复杂疑难肝胆胰腺疾病外科手术、射频消融、综合介入及腹腔镜微创外科专业于一体,已形成一定区域优势,辐射省内多个地区。科室医护人员近年来发表学术论文100余篇,获省、市级科技进步奖3项,目前承担国家卫计委课题1项,河南省教育厅、科技厅、卫生厅课题3项。 诊疗范围: 肝脏疾病:原发性肝癌;继发性肝癌;肝血管瘤;肝破裂;肝脓肿;肝囊肿等。 胆道疾病:肝门部胆管癌;胆囊癌;胆囊结石;胆囊炎;胆囊息肉;肝内外胆管结石;先天性胆管囊肿;梗阻性黄疸;胆道狭窄、损失修复、整形及重建等。 胰腺疾病:胰腺癌;胰腺炎;壶腹部肿瘤;胰管结石;胰岛细胞瘤;胰腺内分泌肿瘤;胰腺 假性囊肿等。 脾脏疾病:脾脏肿瘤;脾脓肿;脾囊肿;脾脏破裂;脾功能亢进; 上消化道出血;门静脉高压;布加氏综合征等。其他疾病:腹股沟疝、直疝、切口疝;甲状腺肿瘤;腹部外伤;急腹症;阑尾炎等。
专家介绍:陈艳军

肝胆胰腺外科 主任
主任医师 医学博士 硕士生导师
河南省临床肿瘤学会胆胰肿瘤分会副主任委员,河南省抗癌协会胆道肿瘤专委会常委, 河南省抗癌协会肿瘤热疗专委会常委, 河南省抗癌协会肿瘤支持治疗专委会常委, 河南省抗癌协会肿瘤消融专委会常委,河南省消化医学学会肝癌MDT专委会常委,河南省医学会微创外科学分会委员,河南省医师协会肝胆外科专委会青年委员,河南省医师协会脾脏与门静脉高压外科专委会委员。长期承担郑州大学本科生及研究生的教学工作。
主要成果:近年来发表专业学术论文30余篇,SCI论文1篇,参编专业著作2部,参与完成省级课题2项,卫生部课题2项,省级课题3项, 获省级科技成果1项。
擅长:擅长开腹或腹腔镜微创手术治疗以下疾病:原发性肝癌、肝血管瘤等肝脏各种良恶性肿瘤,肝内外胆管结石、胆管癌等复杂胆道疾病,胰头癌、胰腺体尾部癌等胰腺肿瘤,同时在肝动脉栓塞化疗(TACE)治疗中晚期肝癌、肝动脉栓塞化疗+腹腔动脉化疗治疗中晚期胰腺癌尤其是合并有肝转移的晚期胰腺癌方面,以及局部进展期胰腺癌(LAPC)和不可切除的肝门部胆管癌的纳米刀(Nano knife)消融治疗方面积累了丰富的经验,近年来,在急性重症坏死性胰腺炎的腹膜后入路微创治疗方面取得新的突破。
供稿:肝胆胰腺外科 陈艳军





